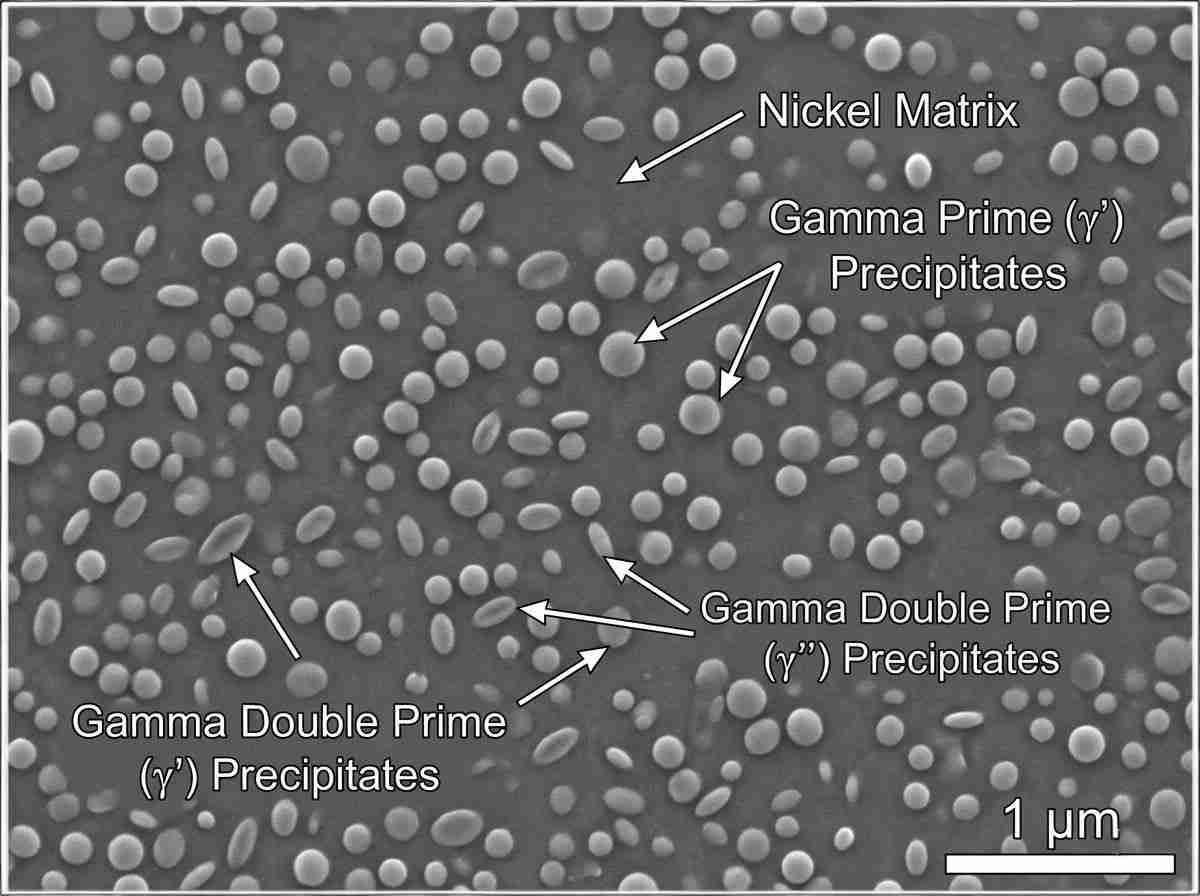
수율별 니켈 합금 기계적 강도 비교

초심해 사워 가스 유정부터 초임계 가스 터빈의 연소실에 이르기까지 점점 더 가혹한 환경에서 부품이 작동하는 경우 재료 선택은 추측에 의존해서는 안 됩니다. 엔지니어링 팀은 극한의 온도와 부식성 매체에서 복잡한 다축 하중을 견디는 소재를 지정해야 한다는 엄청난 압박에 직면해 있습니다. 치명적인 수율 저하 또는 조기 피로 균열을 방지하려면 세심한 니켈 합금 기계적 강도 비교가 필수입니다. 특정 합금 원소 간의 미묘한 상호 작용은 특정 내부 매트릭스가 작동 하중 하에서 전단, 크리프 또는 치명적인 파괴를 일으킬지 여부를 결정합니다.

고체 솔루션 대 강수량 경화
구조적 무결성에 대한 다양한 등급을 평가할 때 유효한 니켈 합금 기계적 강도를 비교하려면 먼저 주요 강화 메커니즘에 따라 재료를 분류해야 합니다. Alloy 600과 같은 고용체 강화 합금 또는 하스텔로이 C-276, 는 전적으로 원자 격자 왜곡에 의존합니다. 원자 반경이 더 큰 원소, 특히 몰리브덴과 텅스텐은 면 중심 입방체(FCC) 니켈 매트릭스에 용해됩니다. 이러한 크기 불일치는 전위 이동을 방해하는 국부적인 내부 변형 필드를 생성하여 적당한 항복 강도와 함께 뛰어난 기준 연성을 제공합니다.
반대로 작동 봉투에 100ksi(690MPa) 이상의 항복 강도가 필요한 경우, 강수 경화성(PH) 합금이 필수 선택이 됩니다. 인코넬 718 및 모넬 K-500과 같은 재종은 특정 노화 열처리를 거쳐 미세하게 분산된 금속 간 침전물을 형성합니다. 감마 프라임의 침전물(γ′)-명목상 Ni3(Al,Ti)-및 감마 이중 소수(γ′′)-명목상 Ni3Nb-는 단단한 미세 구조 장벽으로 작용합니다. 전위는 이러한 침전물을 깎아내거나 그 주위를 돌게 되므로(오로완 보잉) 소성 변형이 시작되기 전에 훨씬 더 높은 응력이 가해져야 합니다.
정량적 기준 분석
이론적 야금과 실제 부품 설계 사이의 간극을 정확하게 메우려면 표준 경험적 테스트 데이터를 참조해야 합니다. 위에서 설명한 구조적 차이는 표준 상온 인장 시험에서 명확하게 드러납니다.
| 합금 등급 | 기본 매트릭스 메커니즘 | 항복 강도(0.2% 오프셋) | 최대 인장 강도(UTS) | 연신율 (%) | 일반적인 경도 |
| 합금 400 | 고체 솔루션(Ni-Cu) | 240MPa(35ksi) | 550MPa(80ksi) | 40% | 75 HRB |
| 합금 625 | 고체 솔루션(Ni-Cr-Mo) | 414MPa(60ksi) | 827MPa(120ksi) | 30% | 90 HRB |
| 하스텔로이 C-276 | 고체 솔루션(Ni-Mo-Cr) | 355MPa(52ksi) | 790MPa(115ksi) | 40% | 87 HRB |
| 합금 718(숙성) | 강수량 강화 | 1034 MPa(150 ksi) | 1241 MPa(180 ksi) | 15% | 36 HRC |
| 모넬 K-500(숙성) | 강수량 강화 | 790MPa(115ksi) | 1100 MPa(160 ksi) | 20% | 30 HRC |
크리프 파열 및 고온 성능 저하
실온 데이터는 부분적인 기준선만 제공합니다. 포괄적인 니켈 합금 기계적 강도 비교는 특히 절대 용융 온도의 0.4배를 초과하는 애플리케이션의 경우 크리프라고 하는 시간 의존적 소성 변형을 엄격하게 고려해야 합니다(Tm). 온도가 600°C(1112°F) 이상으로 상승하면 원자 확산 속도가 기하급수적으로 빨라져 일반적으로 주변 온도에서 전위가 차단되는 미세 구조 장애물 위로 전위가 올라갈 수 있습니다. 입자 경계 미끄러짐도 주요 고장 메커니즘이 됩니다.
예를 들어 합금 625는 주변 강도는 견고하지만 항복 강도는 815°C(1500°F) 이상에서 급격하게 떨어집니다. 반면 합금 718은 침전 동역학이 느리기 때문에 노화 없이 최대 650°C(1200°F)까지 구조적 무결성을 장기간 유지할 수 있습니다. 더욱 극한의 고온 응용 분야의 경우, 카바이드 네트워크 강화 및 고체 용액 매트릭스에 크게 의존하는 합금( 하스텔로이 X)은 10,000시간 간격의 장기 크리프 파열 수명 측면에서 강수량이 많은 경화 등급보다 우수한 성능을 발휘하는 경우가 많습니다.
낮은 사이클 피로 및 극저온 인성
표준 니켈 합금 기계적 강도 비교에서 종종 무시되는 또 다른 중요한 엔지니어링 지표는 저주기 피로(LCF)와 극저온 충격에 대한 반응입니다. 왜냐하면 니켈 합금 은 모든 온도에서 FCC 결정 구조를 유지하므로 표준 탄소 및 페라이트계 스테인리스강을 괴롭히는 연성-취성 전이 온도(DBTT)의 영향을 받지 않습니다. 이러한 고유한 격자 안정성 덕분에 Inconel 718 및 Alloy 400과 같은 합금은 액체 질소 또는 액체 수소(-253°C)에 담가도 거의 모든 충격 인성과 균열 전파에 대한 저항성을 유지할 수 있습니다.
운영 무결성 확보
정확한 야금학적 프로파일을 특정 기계적 하중 범위와 일치시키려면 깊이 있는 경험적 통찰력이 필요합니다. 응력, 피로, 심한 부식이 복합적으로 작용하는 안전에 중요한 부품을 설계할 때는 표면적인 니켈 합금 기계적 강도 비교만으로는 충분하지 않습니다. 28Nickel의 야금 엔지니어링 팀은 정기적으로 복잡한 하중 프로파일을 모델링하여 고객을 위한 정확한 고장 위치를 계산합니다. 현재 선택한 재료의 성능이 미흡하거나 차세대 부품을 설계하는 경우 기술 지원 팀에 연락하여 엄격한 데이터 기반 재료 평가를 요청하세요.
관련 Q&A
Q1: 냉간 가공은 니켈 합금 기계적 강도 비교 결과에 어떤 영향을 미칩니까?
냉간 가공(변형 경화)은 전위 밀도와 얽힘을 증가시켜 고용체 합금의 수율과 인장 강도를 모두 크게 증가시킵니다. 예를 들어, 냉간 압연 합금 625는 일부 강수 경화 등급에 필적하는 800MPa에 가까운 항복 강도를 얻을 수 있지만, 전체 연성에 상당한 비용이 발생하고 이방성 기계적 거동을 유발할 수 있습니다.
Q2: 합금 718이 650°C 이상에서 계속 작동하면 강도가 급격히 떨어지는 이유는 무엇인가요?
합금 718의 주요 강화 단계는 감마 이중 프라임입니다(γ′′), 즉 몸체 중심의 사면체 상으로 변합니다. 650°C 이상의 온도에 장시간 노출되면 이 상은 열역학적으로 안정하지만 기계적으로 약한 사방정계 델타 상으로 변합니다(δ) 상으로 변합니다. 이 상 변환은 경화 침전물을 소모하여 항복 강도를 급격히 떨어뜨립니다.
Q3: 경도 시험이 니켈 합금의 항복 강도 평가를 신뢰할 수 있는 대체품인가요?
경도와 최종 인장 강도 사이에는 일반적인 상관관계가 있지만, 경도 값을 사용하여 니켈 초합금의 항복 응력을 추정하는 것은 위험할 정도로 부정확합니다. 복잡한 가공 경화 속도와 미세 구조적 변화(국부적인 탄화물 침전 등)로 인해 동일한 로크웰 경도 값을 가진 두 합금이 다축 장력 하에서 매우 다른 항복점을 나타낼 수 있습니다.



